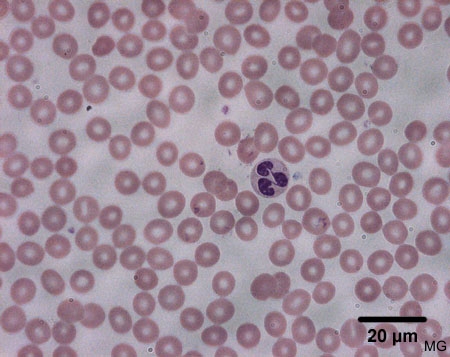

Kuva
Neutrofiili
Verisively, ihminen. Wrightin värjäys.
Kuvassa nähdään neutrofiilinen granulosyytti punasolujen ympäröimänä. Tuma on tyypillisesti useampi lohkoinen. Solulima on heikosti vaaleanpunainen. Solussa on pieniä atsurofiilisiä jyväsiä. 
Neutrofiili








